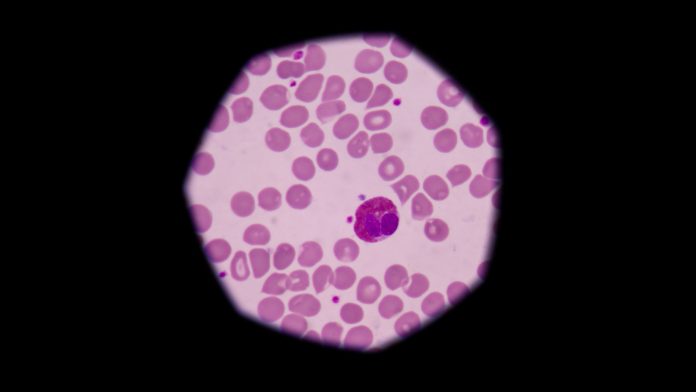

When it comes to your health, knowledge is power. One crucial aspect that might not be on everyone’s radar is the presence of immature granulocytes. These are a type of white blood cell that plays a significant role in your body’s immune response. In this blog post, we’ll delve into what immature granulocytes are, why they matter, and when their levels might be a cause for concern.
Also Read: Tioconazole vs Miconazole: Choosing the Right Antifungal Treatment
What Are Immature Granulocytes?
To put it simply, granulocytes are a type of white blood cell that form in the bone marrow and are a cornerstone of your body’s immune system. They derive their name from the tiny granules present in their cytoplasm, which contain enzymes and other substances that help in the fight against infections.
Immature granulocytes, as the name suggests, are a less mature form of these cells. They are typically released into the bloodstream when the body senses an infection or inflammation that requires a swift immune response.
The Role of Immature Granulocytes
The main role of immature granulocytes is to fortify your body’s defense against bacterial infections. They do this by swiftly migrating to the site of infection and engulfing harmful bacteria. This action helps to contain and eventually eradicate the infection.
Normal Levels vs. Abnormal Levels
In a standard blood test, you might see a value known as the “absolute immature granulocyte count.” This indicates the number of immature granulocytes present in a specific volume of blood.
Normal values for immature granulocytes generally fall below 0.5%. Elevated levels of immature granulocytes may indicate an ongoing infection, inflammation, or another underlying health issue. Conversely, low levels might be attributed to certain medical treatments or conditions.
Causes of Elevated Immature Granulocyte Levels
Several factors can lead to an increase in immature granulocyte levels. These include:
- Bacterial Infections: The most common cause of elevated immature granulocyte levels is a bacterial infection. The body responds by releasing more immature granulocytes to combat the invading pathogens.
- Inflammatory Conditions: Conditions like rheumatoid arthritis, Crohn’s disease, or certain types of cancers can lead to an increase in immature granulocytes.
- Medications: Some medications, especially those that stimulate the production of white blood cells, can lead to higher levels of immature granulocytes.
- Bone Marrow Disorders: Conditions affecting the bone marrow, such as leukemia or myelodysplastic syndrome, can lead to an abnormal increase in immature granulocytes.
When to Seek Medical Attention
If your blood test reveals abnormal levels of immature granulocytes, it’s important not to panic. Many factors can influence these levels, and only a healthcare professional can provide an accurate diagnosis. Nevertheless, if you experience unexplained symptoms like persistent fever, fatigue, or unusual bruising, seeking medical attention promptly is advisable.
In conclusion, understanding immature granulocytes and their role in your immune system empowers you to take charge of your health. Regular check-ups and open communication with your healthcare provider are key to maintaining a strong and resilient immune system.
Remember, knowledge is the first line of defense when it comes to your well-being. Stay informed, stay healthy!